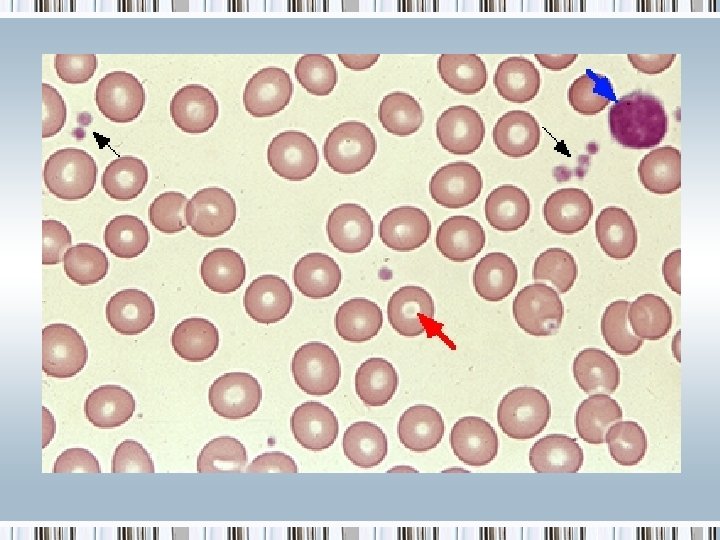
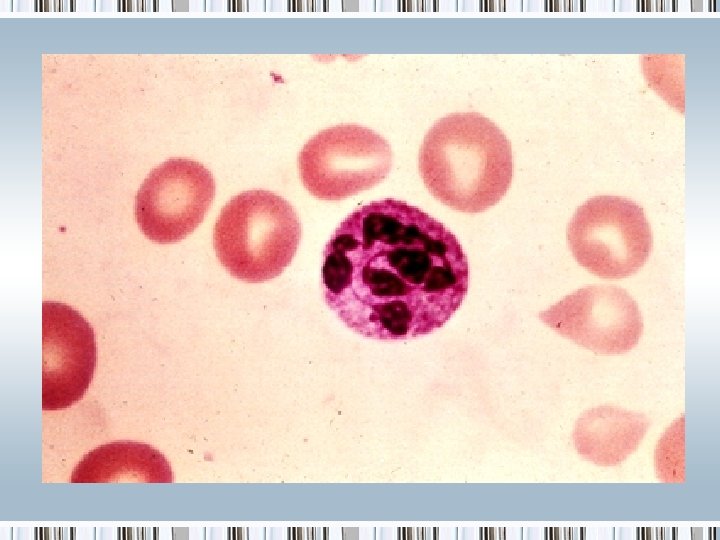
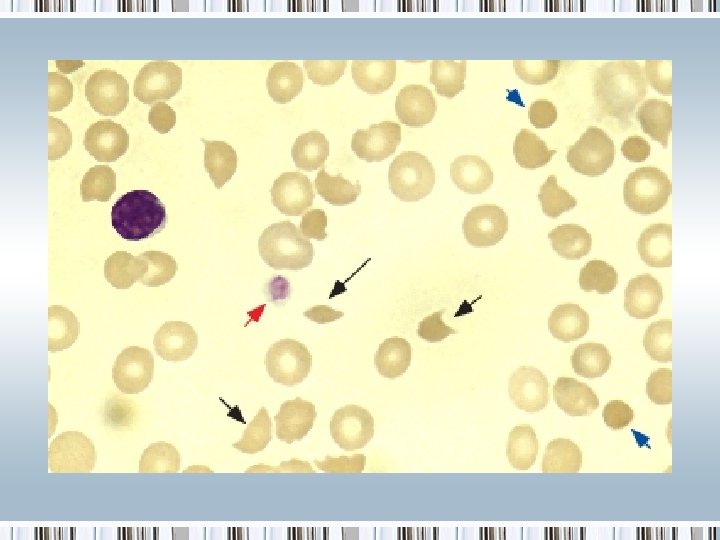
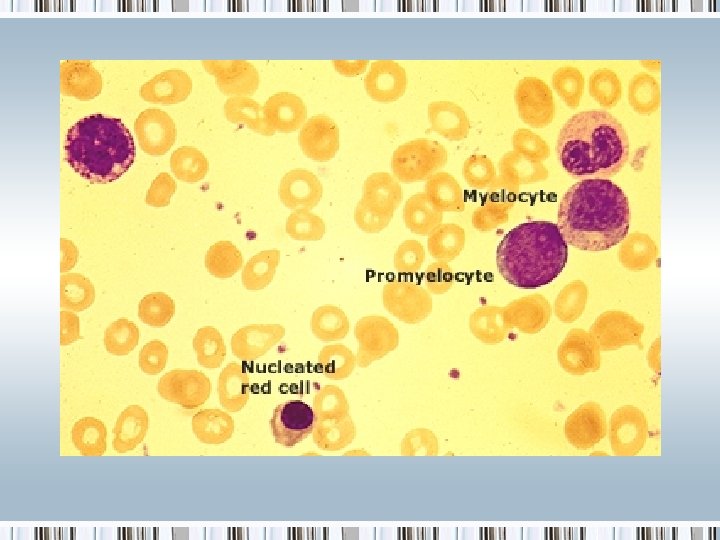
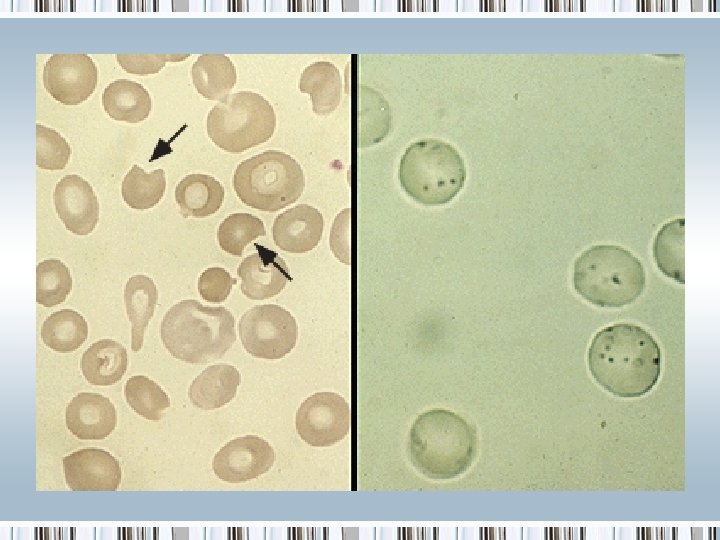
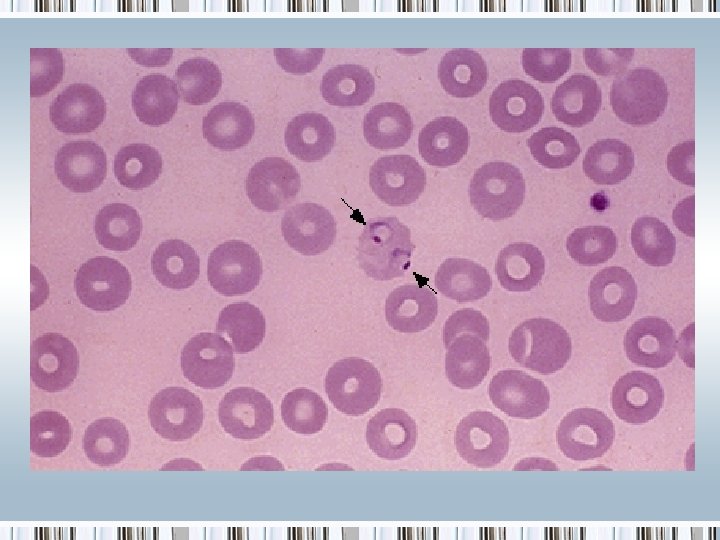
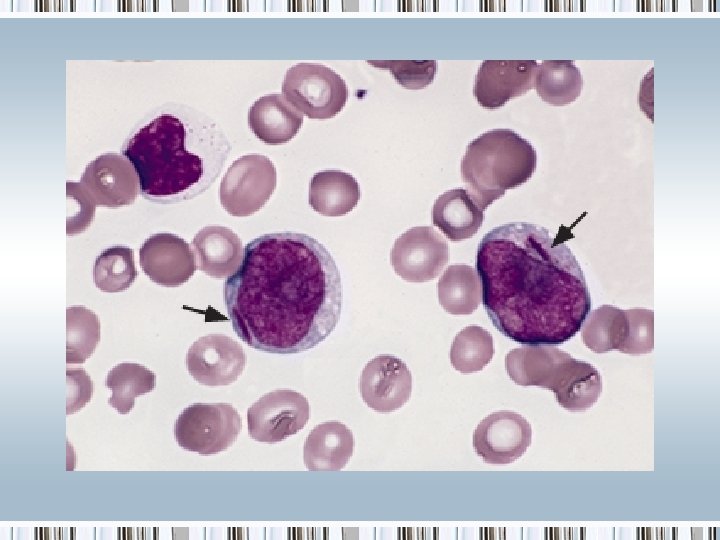
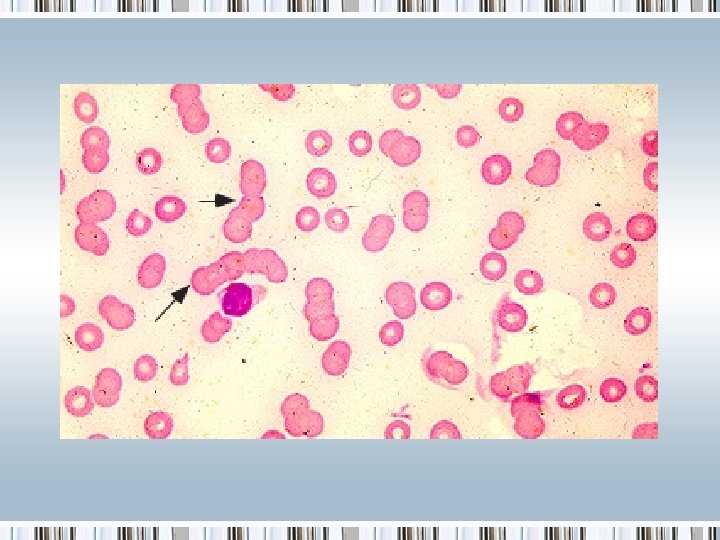

Approach to Anemia Sadie T Velsquez M D






























- Slides: 30

Approach to Anemia Sadie T. Velásquez, M. D.

Objectives

Causes of Anemia Two general approaches can help identify the etiology: • A kinetic approach: decreased RBC production, increased RBC destruction, blood loss • A morphologic approach: categorizes via alterations in RBC size and reticulocyte response

Kinetic approach 1. Decreased RBC production • • • Lack of nutrients: iron, B 12, folate Bone marrow disorders Bone marrow suppression Low levels of trophic hormones (EPO, thyroid, androgens) Anemia of chronic disease/inflammation secondary to reduced availability of iron, relative reduction in EPO and mild reduction in RBC lifespan 2. Increased RBC destruction 3. Blood loss


Morphologic approach The normal RBC has a volume of 80 -96 f. L and a diameter of approximately 7 -8 microns, equal to that of the nucleus of a small lymphocyte. 1. Macrocytic anemia: MCV >100 f. L 2. Microcytic anemia: MCV <80 f. L 3. Normocytic anemia: can be narrowed by examination of the blood smear to assess if patient could be placed in the above categories or by use of the kinetic approach

Evaluation of the patient Questions to address: • Is the patient bleeding? • Is there evidence for increased RBC destruction? • Is there marrow suppression? • Iron deficient and why? • Deficient in folic acid or vitamin B 12 and why?

History and Physical Exam • Is there a history of/or symptoms of a medical condition known to cause anemia? • Is the anemia recent, subacute or lifelong? • Ethnicity and country of origin • Medication use, alcohol • History of transfusions, liver disease, herbal use, exposure to toxins • Pallor • Jaundice

Laboratory Evaluation • CBC • Platelet count • Thrombocytopenia can be seen with hypersplenism, marrow involvement with malignancy, autoimmune platelet destruction, sepsis, or folate or cobalamin deficiency • Blood smear

Laboratory Evaluation • RBC indices • MCV: >115 f. L almost always B 12 or folic acid deficiency • MCH: low values seen in iron deficiency and thalassemia • MCHC: low values occur in the same conditions that generate low values for MCV and MCH; increased values occur in the presence of congenital or acquired spherocytosis or other congenital hemolytic anemias

Laboratory Evaluation • Reticulocyte count: either as % of all RBCs, absolute retic count, corrected absolute retic count, or as retic index. • High retic count reflects increased erythropoietic response to continued hemolysis or blood loss • Low retic count with stable anemia is likely deficient production of RBCs • Hemolysis or blood loss can be found with low retic count if there is a concurrent disorder that impairs production of RBCs • Low retic % accompanied by pancytopenia is suggestive of aplastic anemia; a retic % of zero with normal WBC and platelet counts suggest pure red cell aplasia.


• Absolute reticulocyte count: normal RBC count is 5, 000/micro. L and the normal reticulocyte value is 1 ± 0. 5%; thus, the normal ranges from 25 -75, 000/micro. L • Corrected reticulocyte count: absolute reticulocyte count divided by the reticulocyte maturation time (days) • Reticulocyte production index: makes two corrections, one for the degree of anemia (normalized to a HCT of 45 percent) and another for the reticulocyte maturation time (RMT). The normal RPI is approximately 1. 0. If > 2. 0, it is considered increased. RPI = Retics (%) x (HCT/45) x (1/RMT)

Laboratory Evaluation • WBC differential • Low WBC count with anemia → consider bone marrow suppression or replacement, hypersplenism or deficiencies of cobalamin or folate • High WBC count → consider infection, inflammation, hematologic malignancy • Increased ANC → infection • Increased absolute monocyte count in myelodysplasia • Increased absolute eosinophil count in certain infections • Decreased ANC following chemotherapy • Decreased absolute lymphocyte count in HIV infection or following steroids • Neutrophil hypersegmentation (>5% of neutrophils with ≥ 5 lobes and/or the presence of ≥ 1 with ≥ 6 lobes) seen with impaired DNA synthesis.

Laboratory Evaluation • Pancytopenia: the combination of anemia, thrombocytopenia, and neutropenia. Severe pancytopenia narrows the differential to aplastic anemia, folate or cobalamin deficiency or hematologic malignancy.

• Evaluation for iron deficiency: if history and prelim laboratory data suggestive, check iron, transferrin, transferrin saturation, ferritin. • Evaluation for hemolysis: if rapid fall in Hb, reticulocytosis, abnormal smear, check LDH, indirect bili and haptoglobin. • Bone marrow examination: indications for examination of the bone marrow in anemic patients include pancytopenia or the presence of abnormal cells in the circulation (blast forms).


Smears

References • Schrier, S. ‘Approach to the adult patient with anemia’. Up. To. Date. 26 September 2011. http: //www. uptodate. com/contents/approach-tothe-adult-patient-withanemia? source=search_result&search=pancytope nia&selected. Title=3~150